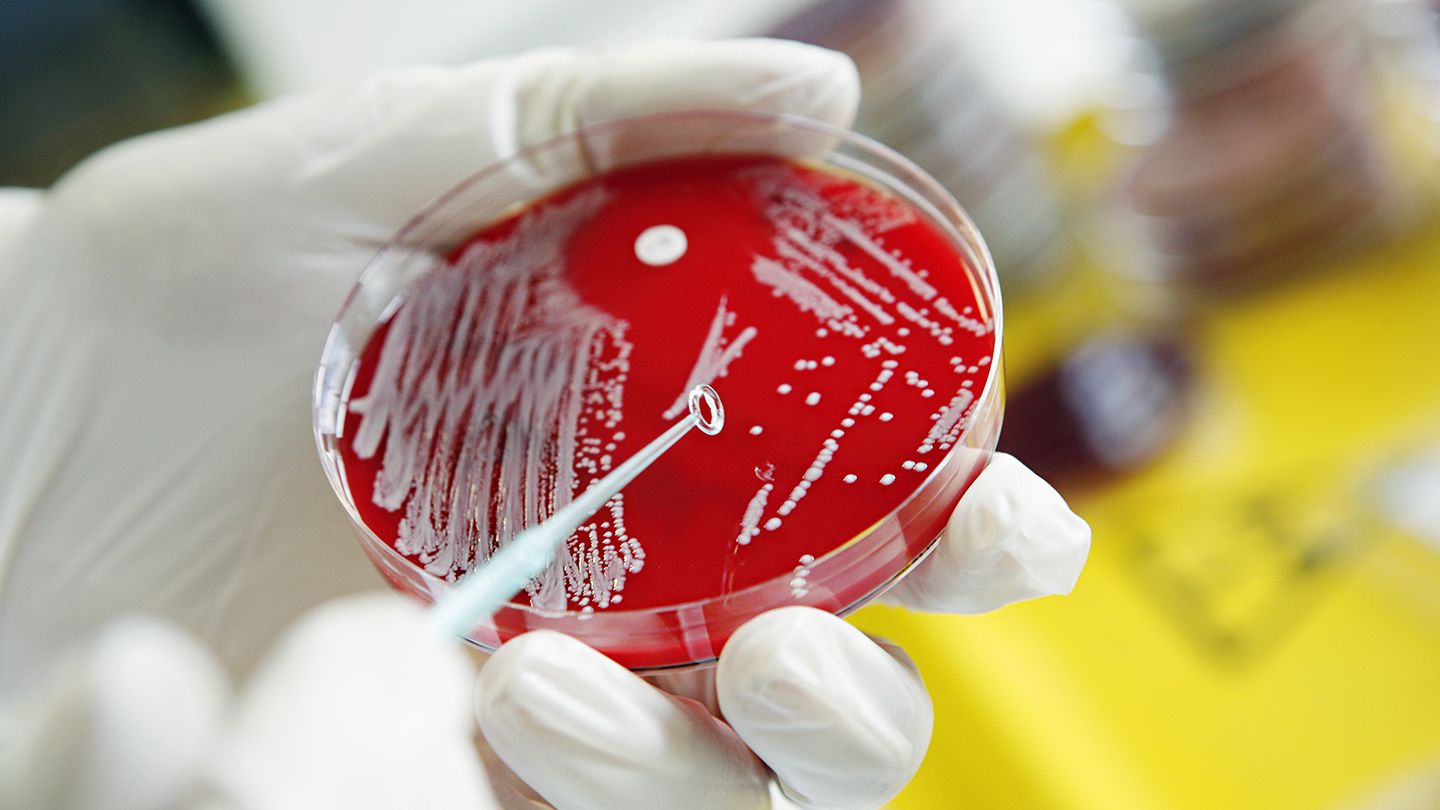
Deadly diseases

There are a number of diseases that can result in swift and severe consequences that could result in death. It’s crucial to remember that the rate at which a disease develops might vary based on a number of variables, including a person’s health, medical interventions, and access to healthcare. Here are a few illnesses that have a history of being extremely aggressive:
Acute Myeloid Leukemia (AML): AML is a blood and bone marrow-related malignancy. This disease can advance quickly, causing symptoms including exhaustion, frequent infections, and simple bleeding or bruising.
Heart Attack: A heart attack happens when the blood supply to the heart muscle is cut off, causing tissue damage. If the disease is not treated very away, severe complications and even unexpected death may occur.
Ebola: The Ebola virus disease is a serious and frequently fatal condition marked by organ failure, haemorrhage, and fever. It has a high fatality rate, and in certain outbreaks, infection has been followed by death a few days to a few weeks later. Good cleanliness, avoiding contact with infected people or animals, and strictly adhering to infection control protocols in healthcare settings are also crucial Ebola prevention measures.
Mycobacterium Tuberculosis: Mycobacterium tuberculosis is the infectious disease that causes tuberculosis (TB). Although it can affect other body regions, it typically affects the lungs. If untreated, TB can advance quickly and be lethal. Early detection is achieved by routine screenings, active cases are treated quickly, and infection control procedures are implemented in hospital settings.
Rabies Infects: The virus that causes rabies infects the central nervous system. As symptoms start to develop, the disease advances quickly, causing unconsciousness and death in a couple of days. However, symptoms can be avoided by seeking medical help right away after exposure.
Acute Pancreatitis: Although there are several levels of pancreatitis severity, acute pancreatitis can be fatal. It is characterised by a sudden onset of pancreatic inflammation, which causes excruciating stomach discomfort, organ failure, and infection. In severe situations, problems may emerge quickly and cause death.
You can read more of such stories at Credible News.
- Cardiac Arrest, Heart Attack: The Causes and Cure
- Reasons For Fading Love In Marriage
- Causes and Cure For Twitching Eyelid
COVID-19: The SARS-CoV-2 new coronavirus is the cause of COVID-19. Although moderate cases predominate, severe cases of this disease can advance quickly, especially in people with underlying medical issues. Vaccination, wearing masks in crowded areas or when advised, using proper hand hygiene, keeping a physical distance from others, and according to regional health regulations are all examples of preventive methods.
Flu: Often known as the “flu,” this contagious respiratory ailment has the potential to be fatal. A yearly flu shot is a useful preventative measure. The flu can also be stopped from spreading by keeping your hands clean, covering your mouth and nose when you cough or sneeze, and avoiding close contact with ill people.
Creutzfeldt-Jakob disease (CJD): Prions are aberrant proteins that cause CJD, a rare degenerative brain condition. Rapid mental decline, neurological problems, and ultimately death follow. The condition may advance over a period of months to several years.
Fulminant Hepatitis: A severe form of liver inflammation that can advance quickly, fulminant hepatitis can be fatal. Rapid liver failure brought on by it results in coagulopathy, multiorgan failure, and encephalopathy. It can be lethal within days to weeks if appropriate medical attention is not received. Hepatitis B and C: Hepatitis B and C are viral infections primarily affecting the liver. They can lead to chronic liver disease, cancer, and even death. Vaccination against hepatitis B is available and recommended. Preventive measures for hepatitis B and C include practising safe sex, avoiding sharing needles, and taking precautions to prevent contact with infected blood or bodily fluids.
Acute Respiratory Distress Syndrome (ARDS): ARDS is a serious lung condition that can be brought on by a number of things, such as pneumonia, serious infections, or lung damage. If not treated right away, the disease can induce fast breathing difficulties, low oxygen levels, and organ failure, which can be fatal. Preventive measures include prompt treatment of underlying conditions, infection control measures, and early recognition and management of respiratory symptoms.
Meningococcal Meningitis: A bacterial illness called meningococcal meningitis causes inflammation of the membranes that surround the brain and spinal cord. The disease can advance quickly, producing symptoms including a terrible headache, a fever, a stiff neck, and a distinctive rash. Untreated, it might result in shock and organ failure. Vaccination against meningococcal serogroups and practising good respiratory hygiene are important preventive measures.
Necrotizing Fasciitis: Also known as flesh-eating bacteria, necrotizing fasciitis is a bacterial illness that quickly spreads and kills soft tissue. If not treated right away, the disease can cause sepsis and multiple organ failure.
Sepsis: The body’s excessive response to an infection results in this potentially fatal disease. Rapid progression might cause organ failure, septic shock, and even death. Antibiotics and supportive care must be administered to patients with sepsis right away. Preventive measures include promptly treating infections, practising good hygiene, and ensuring appropriate wound care. Early recognition and treatment of sepsis symptoms are vital.
It’s critical to keep in mind that early diagnosis, appropriate care, and access to healthcare can have a big impact on how many diseases turn out. For the greatest chance of recovery, it is essential to identify symptoms as soon as possible and seek prompt medical assistance.
Malaria: Malaria is a parasite-borne disease that is spread by mosquitoes. If not treated right once, it can develop quickly and result in serious consequences. While travelling to regions where malaria is endemic, you should use insect repellent, sleep under bed nets sprayed with insecticide, and take antimalarial drugs.
HIV/AIDS: Acquired immunodeficiency syndrome is a condition caused by the Human Immunodeficiency Virus (HIV), which destroys the immune system (AIDS). If HIV is not treated, the disease can spread quickly, and complications from AIDS can be fatal. Safe sexual behaviour, the use of sterilised needles when taking drugs, and routine HIV testing are all HIV prevention strategies.
Hantavirus: Hantavirus is a rare but serious respiratory disease that can infect rodents and spread to humans, causing Hantavirus pulmonary syndrome (HPS). It may advance quickly and cause respiratory failure. Minimizing interaction with rodents, plugging up any possible rodent access sites in homes or buildings, and following the right cleaning and disinfection processes are all examples of preventive measures.
Marburg Virus Disease (MVD): The Marburg virus disease is a highly contagious illness with a high fatality rate, much like Ebola. Direct contact with bodily fluids of infected people or exposure to contaminated things are the two main ways HIV spreads. The use of personal protective equipment in hospital settings, proper hand hygiene practises, and tight infection control procedures are all examples of preventive measures.
Dengue Fever: A virus called dengue is spread by mosquitoes. The disease can develop quickly and result in serious complications like dengue hemorrhagic fever, which can be fatal. Reduced mosquito breeding areas, the use of insect repellents, wearing protective clothing, and the use of mosquito nets are all examples of preventive methods.
Tetanus: Tetanus is a dangerous bacterial disease that can cause muscle stiffness and spasms. It also affects the nervous system. It can develop quickly and be lethal. Tetanus can be avoided by getting vaccinated, making sure that wounds are properly cleaned and cared for, and getting booster shots when necessary.
Nipah Virus Infection: Nipah virus is a zoonotic virus that can cause severe respiratory disease and encephalitis in humans. It is transmitted through direct contact with infected animals, usually fruit bats, or through close contact with infected humans. Preventive measures include avoiding contact with infected animals, practising good hygiene, and implementing appropriate infection control measures in healthcare settings.
Crimean-Congo Hemorrhagic Fever (CCHF): CCHF is a viral hemorrhagic fever transmitted to humans through tick bites or direct contact with infected animal blood or tissues. Preventive measures for the disease include using tick repellents, wearing protective clothing in high-risk areas, avoiding contact with blood or tissues of infected animals, and implementing proper infection control precautions in healthcare settings.
The key to addressing these disorders is prevention. While visiting areas where specific diseases are widespread, it’s critical to adhere to recommended immunisation schedules, practise good hygiene, keep a healthy lifestyle, and take the required measures. Moreover, prompt diagnosis and therapy depend on obtaining medical help as soon as symptoms appear.
You can read more of such stories at Credible News and The Cheer News.